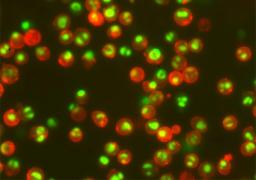

NucView® Caspase-3 Enzyme Substrates
Fluorescent caspase-3/7 substrates for detecting apoptosis in intact cells by confocal microscopy, flow cytometry, or live cell imaging.
NucView® Caspase-3 Substrates are a convenient tool for detecting apoptosis in intact cells based on caspase-3/7 activity using confocal microscopy, flow cytometry, or live cell imaging.
- Rapid, no-wash, endpoint or real-time assays
- Non-toxic, allowing multi-day experiments to be performed
- Available in green, blue, or orange fluorescence
- For flow cytometry, microscopy or live cell imaging systems
- Dual detection of caspase activity and nuclear morphology
- Formaldehyde fixable
NucView® 405 Caspase-3 Substrate, 1 mM in DMSO #10405
NucView® 405 Caspase-3 Substrate, 1 mM in DMSO, Trial Size #10405-T
NucView® 405 Caspase-3 Substrate, 1 mM in 1X PBS #10407
NucView® 405 Caspase-3 Substrate, 1 mM in 1X PBS, Trial Size #10407-T
NucView® 530 Caspase-3 Substrate, 1 mM in DMSO #10406
NucView® 530 Caspase-3 Substrate, 1 mM in DMSO, Trial Size #10406-T
NucView® 530 Caspase-3 Substrate, 1 mM in 1X PBS #10408
NucView® 530 Caspase-3 Substrate, 1 mM in 1X PBS, Trial Size #10408-T
NucView® 488 Caspase-3 Substrate, 1mM in 1X PBS #10403
NucView® 488 Caspase-3 Substrate, 1mM in 1X PBS #10403-T
NucView® 488 Caspase-3 Substrate, 1mM in DMSO #10402
NucView® 488 Caspase-3 Substrate, 1mM in DMSO #10402-T